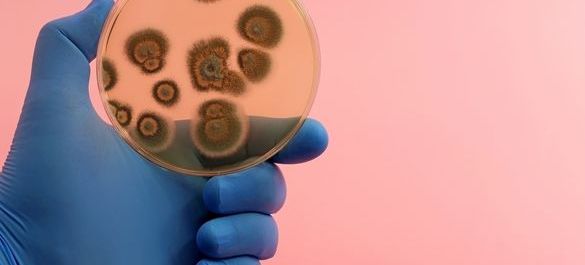
iStock-1477073410.jpg

Infection Science
Explore our policy work on infection science
The Microbiology Society has expert members that work on clinical microbiology, diagnostics, emerging diseases and immunology. We provide expert microbiological evidence and opinion to policymakers at the forefront of health policy.
Consultation responses
-
House of Commons Science and Technology Committee: Emerging Diseases and Learnings from COVID-19 Inquiry
The House of Commons Science and Technology Committee has launched an inquiry on emerging diseases and lessons learned from COVID-19 to identify areas of weakness to ensure the UK is well placed tackle future public health emergencies. We consulted with members that were involved in the national response to the pandemic and submitted a cohesive response from the Microbiology Society community.
-
House of Commons Science and Technology Committee: Science in Emergencies and UK Lessons from Ebola
The House of Commons Science and Technology Committee launched an inquiry to examine what lessons had been learned from the Ebola outbreak in West Africa, regarding the use of scientific expertise in the UK for similar disease outbreak emergencies in the future.
Briefings
-
Tuberculosis Explainer
Tuberculosis is a bacterial disease that caused illness in an estimated 8.8 million people globally in 2010 and led to 1.45 million deaths.
-
Human Fungal Diseases
Over a billion people suffer from superficial fungal infections, such as athlete’s foot and thrush worldwide, while life-threatening fungal infections cause an estimated 1.5 million deaths worldwide each year. This briefing outlines the important, but often overlooked, burden of human fungal diseases on public health.
-
Emerging Zoonotic Diseases
Emerging zoonotic diseases are infectious diseases that can be transmitted between vertebrate animals and humans, which have been newly identified, or are increasing in incidence or geographic range. Examples include Ebola, avian influenza and West Nile virus. They pose threats to global public health and economic security.
Image Credits
iStock/vv shots
iStock/stock devil
iStock/Diy13
iStock/TopMicrobialStock
iStock/Kamionsky